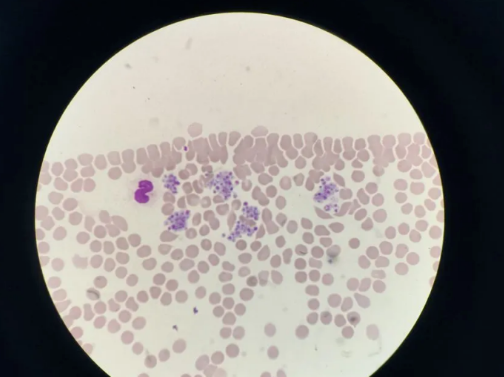

您好!當(dāng)您完成采血離開窗口時(shí),這管承載著健康密碼的血液標(biāo)本,正在檢驗(yàn)科開啟一場精密嚴(yán)謹(jǐn)?shù)目茖W(xué)之旅。讓我們帶您走進(jìn)幕后,見證生命數(shù)據(jù)的誕生過程:

第一站
智能物流傳輸
采血窗口的每一支真空采血管都將通過專屬物流通道直達(dá)檢驗(yàn)科,杜絕"張冠李戴"。氣動物流傳輸系統(tǒng)在15分鐘內(nèi)將標(biāo)本送達(dá)檢驗(yàn)科,確保細(xì)胞活性。

第二站
標(biāo)本預(yù)處理中心
接收窗口的檢驗(yàn)醫(yī)師如同標(biāo)本"質(zhì)檢員",通過LIS系統(tǒng)雙人核對:檢查采血量是否達(dá)標(biāo)(誤差需<5%)、是否溶血或乳糜、抗凝劑比例是否正確。特殊標(biāo)本立即進(jìn)入37℃恒溫震蕩儀,避免凝血因子降解。

第三站
離心分離藝術(shù)
智能離心機(jī)以3500r/min的轉(zhuǎn)速進(jìn)行15分鐘黃金離心,在精密溫控下將血液分離成淡黃色血清/血漿層、薄如蟬翼的白細(xì)胞層、殷紅的紅細(xì)胞層。這個過程猶如制作分子料理,為后續(xù)檢測提取合格樣本。

第四站
自動化檢測矩陣與質(zhì)量控制
生化流水線:機(jī)械臂精準(zhǔn)吸取樣本,30分鐘完成肝腎功能等32項(xiàng)檢測;
免疫平臺:化學(xué)發(fā)光儀以0.001ng/ml的靈敏度捕捉腫瘤標(biāo)志物;血液分析島:五分類血球儀1分鐘完成18項(xiàng)血常規(guī)+3個散點(diǎn)圖分析;凝血工作站:磁珠法精確測定纖維蛋白原至0.01g/L;質(zhì)量控制:是確保檢驗(yàn)結(jié)果準(zhǔn)確可靠的關(guān)鍵。
在日常工作中,按照標(biāo)準(zhǔn)化流程同步檢測患者樣本與已知濃度的標(biāo)準(zhǔn)物質(zhì)和質(zhì)控品,后者作為“隱形的患者”,監(jiān)測異常波動。持續(xù)、嚴(yán)謹(jǐn)?shù)氖覂?nèi)質(zhì)量控制,保證結(jié)果的精密度和準(zhǔn)確性,為臨床診斷提供可靠支持,讓每一份檢驗(yàn)報(bào)告都能成為患者健康的“晴雨表”。

第五站
審核中樞
檢驗(yàn)醫(yī)師結(jié)合患者歷史數(shù)據(jù)、臨床診斷進(jìn)行三重驗(yàn)證:1. 儀器原始數(shù)據(jù)復(fù)核;2. 項(xiàng)目間邏輯關(guān)系校驗(yàn)(如HGB與RBC比值);3. 異常結(jié)果顯微鏡復(fù)檢(如血小板聚集復(fù)檢)。
第六站
生物安全歸檔
所有標(biāo)本在2-8℃專用冰箱保存7天,條形碼管理系統(tǒng)確保隨時(shí)可溯源復(fù)檢。到期標(biāo)本經(jīng)高壓蒸汽滅菌處理,醫(yī)療廢物追溯系統(tǒng)全程監(jiān)控,杜絕生物污染風(fēng)險(xiǎn)。

檢驗(yàn)科以精準(zhǔn)丈量健康,用數(shù)據(jù)守護(hù)生命。每份報(bào)告背后,是20道質(zhì)控程序、8小時(shí)持續(xù)校準(zhǔn)、3級審核制度的堅(jiān)守,只為給您最可靠的健康答案。
微信掃碼預(yù)約

吉公網(wǎng)安備 22038102000293號 吉ICP備18000181號